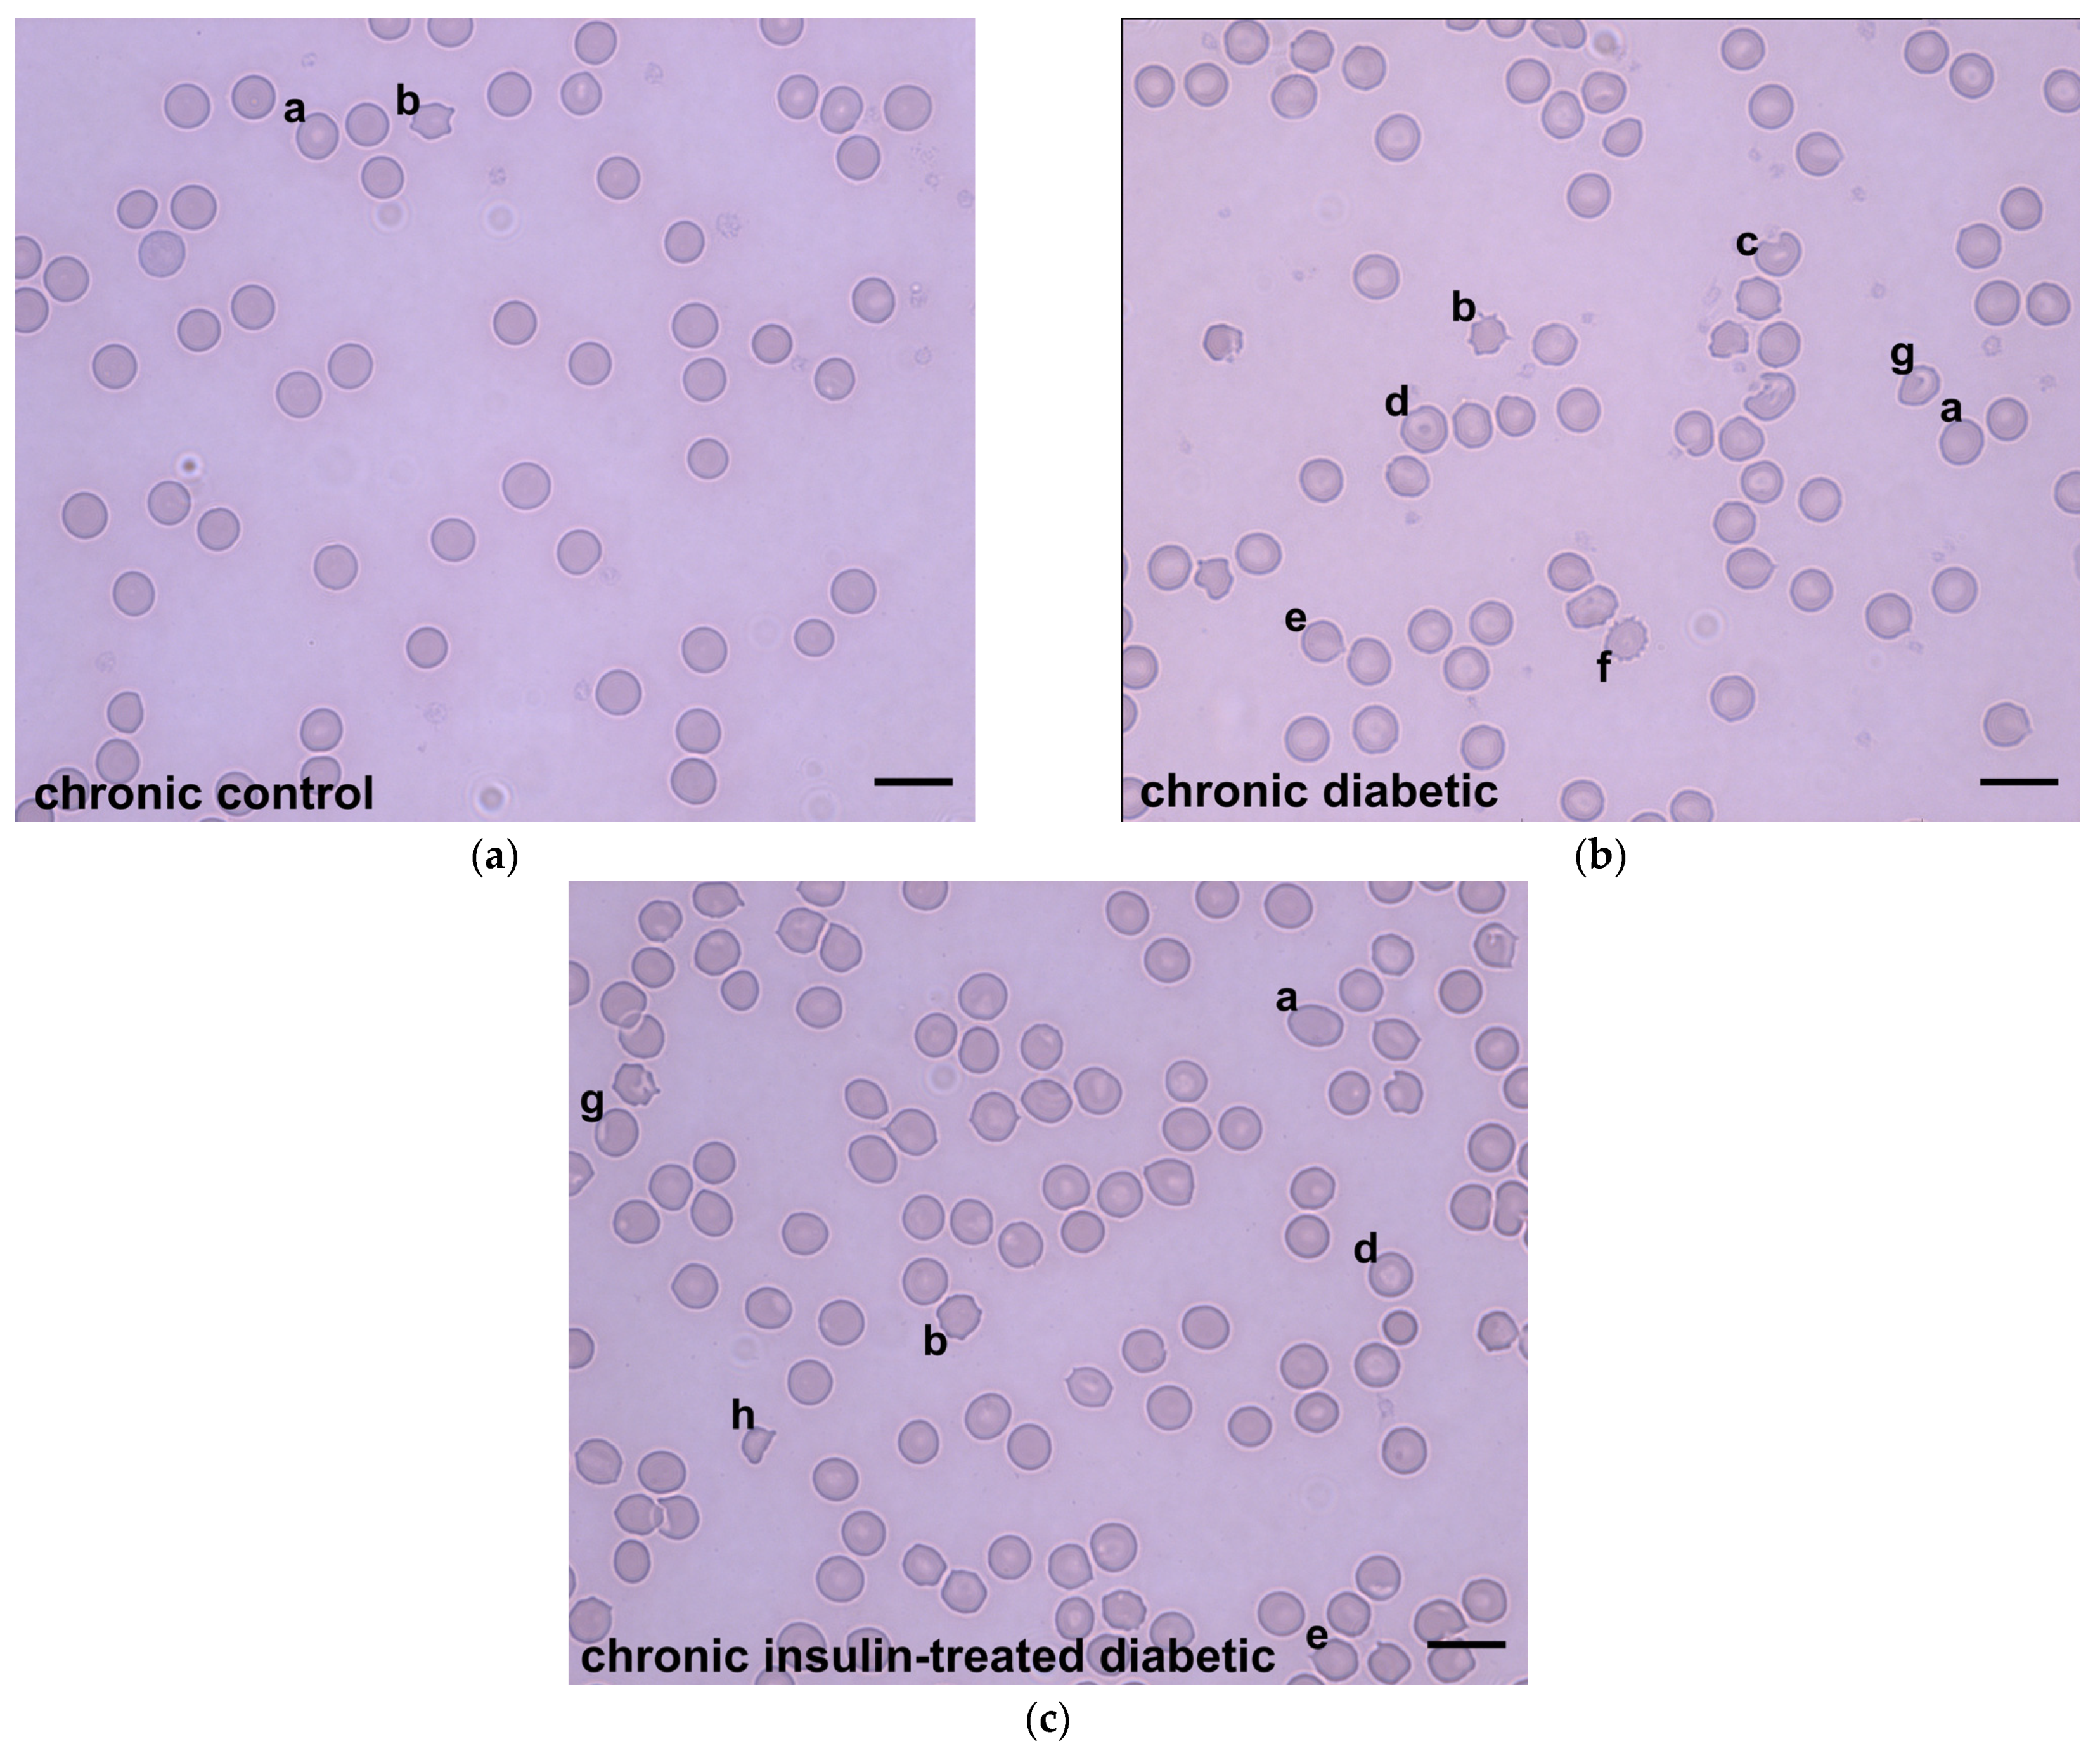
Applsci 13 09920 g004

Oxidative-Stress-Related Alterations in Metabolic Panel, Red Blood Cell Indices, and Erythrocyte Morphology in a Type 1 Diabetic Rat Model
Abstract
:1. Introduction
2. Materials and Methods
2.1. Animal Models
2.2. Determination of Metabolic Panel and Complete Blood Count
2.3. Determination of Diameter and Morphology of Red Blood Cells
2.4. Tissue Handling
2.5. Fluorescent Immunohistochemistry
2.6. Determination of Reduced and Oxidized Glutathione Contents of Red Blood Cells
2.7. Statistical Analysis
3. Results
3.1. Body Weight and Glycemic Characteristics in Diabetic Rats
3.2. Metabolic Panel from Blood and Urine in Diabetic Rats
3.3. Complete Blood Count in Acute and Chronic Diabetic Rats
3.4. Diameter and Morphology of Red Blood Cells
3.5. The Reduced and Oxidized Glutathione Content of Red Blood Cells
4. Discussion
5. Conclusions
Supplementary Materials
Author Contributions
Funding
Institutional Review Board Statement
Informed Consent Statement
Data Availability Statement
Conflicts of Interest
References
- Sarwar, N.; Gao, P.; Seshasai, S.R.; Gobin, R.; Kaptoge, S.; Di Angelantonio, E.; Ingelsson, E.; Lawlor, D.A.; Selvin, E.; Stampfer, M.; et al. Diabetes mellitus, fasting blood glucose concentration, and risk of vascular disease: A collaborative meta-analysis of 102 prospective studies. Lancet 2010, 375, 2215–2222. [Google Scholar] [CrossRef] [PubMed]
- Beckman, J.A.; Creager, M.A. Vascular Complications of Diabetes. Circ. Res. 2016, 118, 1771–1785. [Google Scholar] [CrossRef] [PubMed]
- Zhou, Z.; Mahdi, A.; Tratsiakovich, Y.; Zahorán, S.; Kövamees, O.; Nordin, F.; Uribe Gonzalez, A.E.; Alvarsson, M.; Östenson, C.-G.; Andersson, D.C.; et al. Erythrocytes from Patients with Type 2 Diabetes Induce Endothelial Dysfunction Via Arginase I. J. Am. Coll. Cardiol. 2018, 72, 769–780. [Google Scholar] [CrossRef] [PubMed]
- Palomino-Schätzlein, M.; Lamas-Domingo, R.; Ciudin, A.; Gutiérrez-Carcedo, P.; Marés, R.; Aparicio-Gómez, C.; Hernández, C.; Simó, R.; Herance, J.R. A Translational In Vivo and In Vitro Metabolomic Study Reveals Altered Metabolic Pathways in Red Blood Cells of Type 2 Diabetes. J. Clin. Med. 2020, 9, 1619. [Google Scholar] [CrossRef]
- Alamri, B.; Bahabri, A.; Aldereihim, A.A.; Alabduljabbar, M.; Alsubaie, M.M.; Alnaqeb, D.; Almogbel, E.; Metias, N.S.; A Alotaibi, O.; Al-Rubeaan, K. Hyperglycemia effect on red blood cells indices. Eur. Rev. Med. Pharmacol. Sci. 2019, 23, 2139–2150. [Google Scholar]
- Viskupicova, J.; Blaskovic, D.; Galiniak, S.; Soszyński, M.; Bartosz, G.; Horakova, L.; Sadowska-Bartosz, I. Effect of high glucose concentrations on human erythrocytes in vitro. Redox Biol. 2015, 5, 381–387. [Google Scholar] [CrossRef]
- Wang, Y.; Yang, P.; Yan, Z.; Liu, Z.; Ma, Q.; Zhang, Z.; Wang, Y.; Su, Y. The Relationship between Erythrocytes and Diabetes Mellitus. J. Diabetes Res. 2021, 2021, 6656062. [Google Scholar] [CrossRef]
- Rajab, A.M.; Rahman, S.; Rajab, T.M.; Haider, K.H. Morphology and Chromic Status of Red Blood Cells Are Significantly Influenced by Gestational Diabetes. J. Hematol. 2018, 7, 140–148. [Google Scholar] [CrossRef]
- Turpin, C.; Catan, A.; Guerin-Dubourg, A.; Debussche, X.; Bravo, S.B.; Álvarez, E.; Van Den Elsen, J.; Meilhac, O.; Rondeau, P.; Bourdon, E. Enhanced oxidative stress and damage in glycated erythrocytes. PLoS ONE 2020, 15, e0235335. [Google Scholar] [CrossRef]
- Saleh, J. Glycated hemoglobin and its spinoffs: Cardiovascular disease markers or risk factors? World J. Cardiol. 2015, 7, 449–453. [Google Scholar] [CrossRef]
- Neamţu, M.C.; Crăiţoiu, S.; Avramescu, E.T.; Margină, D.M.; Băcănoiu, M.V.; Turneanu, D.; Danciulescu Miulescu, R. The prevalence of the red cell morphology changes in patients with type 2 diabetes mellitus. Rom. J. Morphol. Embryol. 2015, 56, 183–189. [Google Scholar] [PubMed]
- Taneja, A.; Jagtap, M.; Shukla, S.; Vagha, S. Red Blood Cell Morphology in Diabetic Patients: A Case-control Study. J. Clin. Diagn. Res. 2022, 16, EC01–EC04. [Google Scholar] [CrossRef]
- Xiong, Y.; Uys, J.D.; Tew, K.D.; Townsend, D.M. S-glutathionylation: From molecular mechanisms to health outcomes. Antioxid. Redox. Signal. 2011, 15, 233–270. [Google Scholar] [CrossRef] [PubMed]
- Burak Çimen, M.Y. Free radical metabolism in human erythrocytes. Clin. Chim. Acta 2008, 390, 1–11. [Google Scholar] [CrossRef]
- Izbéki, F.; Wittman, T.; Rosztóczy, A.; Linke, N.; Bódi, N.; Fekete, E.; Bagyánszki, M. Immediate insulin treatment prevents gut motility alterations and loss of nitrergic neurons in the ileum and colon of rats with streptozotocin-induced diabetes. Diabetes Res. Clin. Pract. 2008, 80, 192–198. [Google Scholar] [CrossRef]
- Bódi, N.; Talapka, P.; Poles, M.Z.; Hermesz, E.; Jancsó, Z.; Katarova, Z.; Izbéki, F.; Wittmann, T.; Fekete, E.; Bagyánszki, M. Gut Region-Specific Diabetic Damage to the Capillary Endothelium Adjacent to the Myenteric Plexus. Microcirculation 2012, 19, 316–326. [Google Scholar] [CrossRef]
- Ford, J. Red blood cell morphology. Int. J. Lab. Hematol. 2013, 35, 351–357. [Google Scholar] [CrossRef]
- KT, N.; Prasad, K.; Singh, B.M.K. Analysis of red blood cells from peripheral blood smear images for anemia detection: A methodological review. Med. Biol. Eng. Comput. 2022, 60, 2445–2462. [Google Scholar] [CrossRef]
- Caldin, M.; Carli, E.; Furlanello, T.; Solano-Gallego, L.; Tasca, S.; Patron, C.; Lubas, G. A retrospective study of 60 cases of eccentrocytosis in the dog. Vet. Clin. Pathol. 2005, 34, 224–231. [Google Scholar] [CrossRef]
- Lowry, O.H.; Rosebrough, N.J.; Farr, A.L.; Randall, R.J. Protein measurement with the Folin phenol reagent. J. Biol. Chem. 1951, 193, 265–275. [Google Scholar] [CrossRef]
- Sedlak, J.; Lindsay, R.H. Estimation of total, protein-bound, and nonprotein sulfhydryl groups in tissue with Ellman’s reagent. Anal. Biochem. 1968, 25, 192–205. [Google Scholar] [CrossRef] [PubMed]
- Thorel, F.; Népote, V.; Avril, I.; Kohno, K.; Desgraz, R.; Chera, S.; Herrera, P.L. Conversion of adult pancreatic α-cells to β-cells after extreme β-cell loss. Nature 2010, 464, 1149–1154. [Google Scholar] [CrossRef] [PubMed]
- Saleh, M.; Gittes, G.K.; Prasadan, K. Alpha-to-beta cell trans-differentiation for treatment of diabetes. Biochem. Soc. Trans. 2021, 49, 2539–2548. [Google Scholar] [CrossRef] [PubMed]
- Lu, J.; Jaafer, R.; Bonnavion, R.; Bertolino, P.; Zhang, C.X. Transdifferentiation of pancreatic α-cells into insulin-secreting cells: From experimental models to underlying mechanisms. World J. Diabetes 2014, 5, 847–853. [Google Scholar] [CrossRef] [PubMed]
- Bamanikar, S.; Bamanikar, A.; Arora, A. Study of Serum urea and Creatinine in Diabetic and non-diabetic patients in in a tertiary teaching hospital. J. Med. Res. 2016, 2, 12–15. [Google Scholar] [CrossRef]
- Møller, N.; Nair, K.S. Diabetes and Protein Metabolism. Diabetes 2008, 57, 3–4. [Google Scholar] [CrossRef]
- Abu-Lebdeh, H.S.; Nair, K.S. Protein metabolism in diabetes mellitus. Baillieres Clin. Endocrinol. Metab. 1996, 10, 589–601. [Google Scholar] [CrossRef]
- Mohamed, J.; Nazratun Nafizah, A.H.; Zariyantey, A.H.; Budin, S.B. Mechanisms of Diabetes-Induced Liver Damage: The role of oxidative stress and inflammation. Sultan Qaboos Univ. Med. J. 2016, 16, e132–e141. [Google Scholar] [CrossRef]
- Hasan, H.R.; Abdulsattar, A. Influence of diabetes disease on concentration of total protein, albumin and globulins in saliva and serum: A comparative study. Iraqi Natl. J. Chem. 2015, 15, 1–11. [Google Scholar]
- Adnan Khalaf, M.; Ghassan Zainal, I. Investigation of Antioxidant Markers in Diabetic Patients. Arch. Razi Inst. 2021, 76, 1453–1460. [Google Scholar] [CrossRef]
- Haidara, M.A.; Dallak, M.; El Karib, A.O.; Ellatif, M.A.; Eid, R.A.; Heidar, E.H.A.; Al-Ani, B. Insulin protects against hepatocyte ultrastructural damage induced by type 1 diabetes mellitus in rats. Ultrastruct. Pathol. 2018, 42, 508–515. [Google Scholar] [CrossRef] [PubMed]
- Konsue, A.; Picheansoonthon, C.; Talubmook, C. Fasting Blood Glucose Levels and Hematological Values in Normal and Streptozotocin-Induced Diabetic Rats of Mimosa pudica L. Extracts. Pharmacogn. J. 2017, 9, 315–322. [Google Scholar] [CrossRef]
- Miyagawa, S.-I.; Kobayashi, M.; Konishi, N.; Sato, T.; Ueda, K. Insulin and insulin-like growth factor I support the proliferation of erythroid progenitor cells in bone marrow through the sharing of receptors. Br. J. Haematol. 2000, 109, 555–562. [Google Scholar] [CrossRef] [PubMed]
- Mohamed, J.; Shing, S.W.; Idris, M.H.M.; Budin, S.B.; Zainalabidin, S. The protective effect of aqueous extracts of roselle (Hibiscus sabdariffa L. UKMR-2) against red blood cell membrane oxidative stress in rats with streptozotocin-induced diabetes. Clinics 2013, 68, 1358–1363. [Google Scholar] [CrossRef]
- Engström, K.G.; Ohlsson, L. Morphology and Filterability of Red Blood Cells in Neonatal and Adult Rats. Pediatr. Res. 1990, 27, 220–226. [Google Scholar] [CrossRef]
- Bolotta, A.; Battistelli, M.; Falcieri, E.; Ghezzo, A.; Manara, M.C.; Manfredini, S.; Marini, M.; Posar, A.; Visconti, P.; Abruzzo, P.M. Oxidative Stress in Autistic Children Alters Erythrocyte Shape in the Absence of Quantitative Protein Alterations and of Loss of Membrane Phospholipid Asymmetry. Oxidative Med. Cell. Longev. 2018, 2018, 6430601. [Google Scholar] [CrossRef]
- Senchenkova, E.Y.; Skvertchinskaya, E.; Dobrylko, I.; Sudnitsyna, J.; Gambaryan, S.; Mindukshev, I.; Gavins, F. Experimental oxidative stress-induced death of erythrocytes. FASEB J. 2017, 31, lb761. [Google Scholar]
- Chan, T.K.; Chan, W.C.; Weed, R.I. Erythrocyte hemighosts: A hallmark of severe oxidative injury in vivo. Br. J. Haematol. 1982, 50, 575–582. [Google Scholar] [CrossRef]
- Le Jeune, S.; Sadoudi, S.; Charue, D.; Abid, S.; Guigner, J.-M.; Helley, D.; Bihan, H.; Baudry, C.; Lelong, H.; Mirault, T.; et al. Low grade intravascular hemolysis associates with peripheral nerve injury in type 2 diabetes. PLoS ONE 2022, 17, e0275337. [Google Scholar] [CrossRef]
- Effenberger-Neidnicht, K.; Hartmann, M. Mechanisms of Hemolysis During Sepsis. Inflammation 2018, 41, 1569–1581. [Google Scholar] [CrossRef]
- Kato, G.J.; Steinberg, M.H.; Gladwin, M.T. Intravascular hemolysis and the pathophysiology of sickle cell disease. J. Clin. Investig. 2017, 127, 750–760. [Google Scholar] [CrossRef] [PubMed]
- De Franceschi, L.; Turrini, F.; Honczarenko, M.; Ayi, K.; Rivera, A.; Fleming, M.D.; Law, T.; Mannu, F.; A Kuypers, F.; Bast, A.; et al. In vivo reduction of erythrocyte oxidant stress in a murine model of beta-thalassemia. Haematologica 2004, 89, 1287–1298. [Google Scholar] [PubMed]
- Bódi, N.; Chandrakumar, L.; al Doghmi, A.; Mezei, D.; Szalai, Z.; Barta, B.P.; Balázs, J.; Bagyánszki, M. Intestinal Region-Specific and Layer-Dependent Induction of TNFα in Rats with Streptozotocin-Induced Diabetes and after Insulin Replacement. Cells 2021, 10, 2410. [Google Scholar] [CrossRef] [PubMed]
- Bódi, N.; Mezei, D.; Chakraborty, P.; Szalai, Z.; Barta, B.P.; Balázs, J.; Rázga, Z.; Hermesz, E.; Bagyánszki, M. Diabetes-related intestinal region-specific thickening of ganglionic basement membrane and regionally decreased matrix metalloproteinase 9 expression in myenteric ganglia. World J. Diabetes 2021, 12, 658–672. [Google Scholar] [CrossRef] [PubMed]
- Barta, B.P.; Onhausz, B.; AL Doghmi, A.; Szalai, Z.; Balázs, J.; Bagyánszki, M.; Bódi, N. Gut region-specific TNFR expression: TNFR2 is more affected than TNFR1 in duodenal myenteric ganglia of diabetic rats. World J. Diabetes 2023, 14, 48–61. [Google Scholar] [CrossRef]
- Dhaliwal, G.; Cornett, P.A.; Tierney, L.M., Jr. Hemolytic anemia. Am. Fam. Physician 2004, 69, 2599–2606. [Google Scholar]
- Ferreiro, J.L.; Gómez-Hospital, J.A.; Angiolillo, D.J. Review article: Platelet abnormalities in diabetes mellitus. Diabetes Vasc. Dis. Res. 2010, 7, 251–259. [Google Scholar] [CrossRef]
- Scridon, A.; Perian, M.; Marginean, A.; Vantu, A.; Ghertescu, D.; Fisca, C.; Halatiu, V.; Grigoras, T.; Serban, R.C. Streptozotocin-Induced Diabetes Mellitus—A Paradox of High Intrinsic Platelet Reactivity and Low In Vitro Platelet Aggregation. Acta Endocrinol. 2019, 15, 46–51. [Google Scholar] [CrossRef]
- Waggiallah, H.; Alzohairy, M. The effect of oxidative stress on human red cells glutathione peroxidase, glutathione reductase level, and prevalence of anemia among diabetics. N. Am. J. Med. Sci. 2011, 3, 344–347. [Google Scholar] [CrossRef]
- Dincer, Y.; Akcay, T.; Alademir, Z.; Ilkova, H. Effect of oxidative stress on glutathione pathway in red blood cells from patients with insulin-dependent diabetes mellitus. Metabolism 2002, 51, 1360–1362. [Google Scholar] [CrossRef]

| Morphological Types of RBCs | Definitions of Morphological Abnormalities |
|---|---|
| echinocytes | RBCs have regularly distributed, equally sized, rounded projections on their surface [18] |
| acanthocytes | RBCs have irregularly distributed, variably sized, pointy projections on their surface [17,18] |
| ovalocytes | RBCs have oval shape [18] |
| dacrocytes | RBCs are tapered to a point at one end, resembling the classic artist’s rendition of a drop of water [18] |
| schistocytes | RBCs appear to have been fragmented: they lack the usual circular shape [18] |
| eccentrocytes | RBCs are with a clear crescent-shaped area along one side of the periphery [19] |
| hemolyzed RBCs | RBCs that are destroyed with the release of intracellular material [17] |
| codocytes | RBCs have a central red area within the zone of central pallor [18] |
| Controls (n = 6) | Acute Diabetics (n = 7) | ||
|---|---|---|---|
| Weight (g) | Initial | 303.8 ± 9.46 | 293.0 ± 13.7 |
| Final | 339.5 ± 14.97 | 301.7 ± 11.63 | |
| Blood glucose level (mmol/L) | Initial | 5.5 ± 0.2 | 5.9 ± 0.3 |
| Final (average) | 5.6 ± 0.3 | 20.5 ± 1.3 ****°°°° | |
| Urine glucose level (mmol/L) | Final | 5.6 ± 5.1 | 477.2 ± 42.4 °°° |
| HbA1c (mmol/mol) | Final | 12.0 ± 1.2 | 21.8 ± 1.3 °° |
| HbA1c (%) | Final | 3.3 ± 0.1 | 4.1 ± 0.1 °° |
| Controls (n = 20) | Chronic Diabetics (n = 14) | Insulin-Treated Diabetics (n = 13) | Reverted Diabetics (n = 4) | ||
|---|---|---|---|---|---|
| Weight (g) | Initial | 222.1 ± 16.8 | 222.9 ± 17.2 | 230.2 ± 236 | 204.5 ± 5.9 |
| Final | 460.3 ± 46.9 *** | 354.0 ± 33.2 * | 430.8 ± 41.0 *** | 377.5 ± 26.1 | |
| Blood glucose level (mmol/L) | Initial | 6.0 ± 0.2 | 5.7 ± 0.3 | 6.0 ± 0.2 | 6.7 ± 0.1 |
| Final (average) | 5.7 ± 0.1 | 24.0 ± 0.7 ***°°° | 11.8 ± 0.8 *°°° | a, 23.7 ± 1.2 °° b, 11.3 ± 1.2 | |
| Urine glucose level (mmol/L) | Final | 0.31 ± 0.04 | 503.7 ± 12.3 °°°° | 0.39 ± 0.08 ++++ | - |
| HbA1c (mmol/mol) | Final | 21.0 ± 0.6 | 96.6 ± 9.5 °°° | 23.8 ± 1.6 ++ | 32.8 ± 5.1 |
| HbA1c (%) | Final | 4.1 ± 0.1 | 11.0 ± 0.9 °°° | 4.3 ± 0.1 ++ | 5.1 ± 0.5 |
| Controls (n = 3) | Acute Diabetics (n = 4) | ||
|---|---|---|---|
| Carbamide (mmol/L) | Blood | 9.31 ± 0.97 | 9.61 ± 0.81 |
| Urine | 18.38 ± 2.66 | 456.1 ± 27.84 **** | |
| Albumin (g/L) | Blood | 34.0 ± 0.0 | 31.0 ± 0.41 ** |
| Controls (n = 5–20) | Chronic Diabetics (n = 3–14) | Insulin-Treated Diabetics (n = 4–13) | Reverted Diabetics (n = 3–4) | ||
|---|---|---|---|---|---|
| Carbamide (mmol/L) | Blood | 9.37 ± 0.2 | 10.92 ± 0.42 | 8.0 ± 0.29 *°°° | 9.63 ± 0.44 |
| Urine | 27.43 ± 3.63 | 397.5 ± 26.56 **** | 18.71 ± 2.99 °°°° | - | |
| Creatinine (μmol/L) | Blood | 70.0 ± 6.4 | 83.88 ± 8.33 | 81.89 ± 5.47 | 88.25 ± 2.18 |
| Albumin (g/L) | Blood | 32.27 ± 0.88 | 29.55 ± 0.95 | 30.69 ± 1.15 | 34.0 ± 0.41 |
| Cholesterol (mmol/L) | Blood | 2.19 ± 0.05 | 2.35 ± 0.09 | 2.28 ± 0.09 | 3.26 ± 0.31 ** |
| Triglyceride (mmol/L) | Blood | 2.78 ± 1.26 | 1.94 ± 0.15 | 2.18 ± 0.2 | 2.27 ± 0.38 |
| AST (U/L) | Blood | 143.9 ± 10.47 | 132.0 ± 21.37 | 117.2 ± 8.99 | 117.8 ± 11.35 |
| GPT (U/L) | Blood | 68.22 ± 3.51 | 88.0 ± 7.5 | 61.44 ± 4.96 | 66.5 ± 6.4 |
| ALP (U/L) | Blood | 402.6 ± 26.63 | 1393 ± 184.9 *** | 598.8 ± 91.04 | 423.5 ± 40.19 |
| LDH (U/L) | Blood | 603.4 ± 50.43 | 677.5 ± 30.17 | 616.0 ± 62.53 | 728.3 ± 46.25 |
| Total protein (g/L) | Blood | 65.04 ± 0.72 | 59.89 ± 1.11 ** | 59.54 ± 1.37 ** | 62.67 ± 1.21 |
| Total bilirubin (mg/L) | Blood | 6.11 ± 1.23 | 4.56 ± 1.06 | 3.15 ± 0.52 | 3.13 ± 1.08 |
| Controls (n = 3) | Acute Diabetics (n = 4) | |
|---|---|---|
| Specific gravity | 1.01 ± 0.0 | 1.01 ± 0.0 |
| pH | 7.33 ± 0.17 | 6.38 ± 0.24 * |
| Leukocytes | Negative | negative |
| Nitrite | Negative | negative |
| Ketones | Negative | negative |
| Controls (n = 5) | Chronic Diabetics (n = 3) | Insulin-Treated Diabetics (n = 4) | |
|---|---|---|---|
| Specific gravity | 1.0 ± 0.0 | 1.01 ± 0.0 | 1.0 ± 0.0 |
| pH | 7.1 ± 0.33 | 5.5 ± 0.0 * | 7.0 ± 0.35 ° |
| Leukocytes | negative | Positive | positive |
| Nitrite | negative | Negative | negative |
| Ketones | negative | Negative | negative |
| Controls (n = 3) | Acute Diabetics (n = 4) | |
|---|---|---|
| RBC, Red Blood Cell (×106/μL) | 7.27 ± 0.13 | 7.42 ± 0.08 |
| HCT, Hematocrit (%) | 46.5 ± 0.98 | 49.0 ± 0.85 |
| Hb, Hemoglobin (g/dL) | 14.1 ± 0.21 | 13.75 ± 0.23 |
| MCV, Mean corpuscular volume (fl) | 64.03 ± 2.26 | 66.03 ± 0.84 |
| MCH, mean corpuscular hemoglobin (pg) | 19.4 ± 0.59 | 18.5 ± 0.2 |
| MCHC, Mean corpuscular hemoglobin concentration (g/dL) | 30.3 ± 0.2 | 28.05 ± 0.42 |
| CHCM, Corpuscular hemoglobin concentration mean (g/dL) | 30.2 ± 0.23 | 27.9 ± 0.47 |
| CH, Corpuscular hemoglobin content (pg) | 19.37 ± 0.61 | 18.45 ± 0.14 |
| HDW, Hemoglobin concentration distribution width (g/dL) | 2.2 ± 0.05 | 1.99 ± 0.09 |
| RDW, Red blood cell volume distribution width (%) | 11.53 ± 0.35 | 11.33 ± 0.31 |
| WBC, White blood cell (×103/μL) | 6.09 ± 1.44 | 7.57 ± 1.39 |
| Lymphocyte count (×103/µL) | 4.29 ± 1.4 | 5.47 ± 1.14 |
| Monocyte count (×103/µL) | 0.18 ± 0.04 | 0.29 ± 0.07 |
| Neutrophil count (×103/µL) | 1.2 ± 0.05 | 1.2 ± 0.1 |
| Eosynophil count (×103/µL) | 0.22 ± 0.06 | 0.39 ± 0.14 |
| Basophil count (×103/µL) | 0.04 ± 0.003 | 0.05 ± 0.005 |
| Large unstained cell count (×103/µL) | 0.16 ± 0.06 | 0.17 ± 0.04 |
| PLT, Platelet count (×103/μL) | 663.0 ± 33 | 960.8 ± 181.9 |
| MPV, Mean platelet volume (fl) | 9.03 ± 2.13 | 7.85 ± 0.19 ** |
| Controls (n = 13–18) | Chronic Diabetics (n = 12–13) | Insulin-Treated Diabetics (n = 6–12) | Reverted Diabetics (n = 3–4) | |
|---|---|---|---|---|
| RBC, Red Blood Cell (×106/μL) | 8.43 ± 0.13 | 9.34 ± 0.11 *** | 8.59 ± 0.18 ° | 8.77 ± 0.18 |
| HCT, Hematocrit (%) | 46.94 ± 0.75 | 52.42 ± 0.56 *** | 49.34 ± 1.24 | 50.53 ± 2.37 |
| Hb, Hemoglobin (g/dL) | 14.48 ± 0.21 | 15.74 ± 0.2 ** | 15.11 ± 0.19 | 16.08 ± 0.55 |
| MCV, Mean corpuscular volume (fl) | 55.68 ± 0.53 | 56.13 ± 0.45 | 57.54 ± 0.63 | 57.6 ±1.96 |
| MCH, Mean corpuscular hemoglobin (pg) | 17.18 ± 0.18 | 16.87 ± 0.19 | 17.66 ± 0.24 | 18.33 ± 0.5 |
| MCHC, Mean corpuscular hemoglobin concentration (g/dL) | 30.88 ± 0.35 | 30.03 ± 0.24 | 30.74 ± 0.59 | 31.85 ± 0.5 |
| CHCM, Corpuscular hemoglobin concentration mean (g/dL) | 30.28 ± 0.29 | 29.79 ± 0.15 | 29.72 ± 0.47 | 30.9 ± 0.24 |
| CH, Corpuscular hemoglobin content (pg) | 16.79 ± 0.15 | 16.69 ± 0.1 | 17.02 ± 0.22 | 17.78 ± 0.65 |
| HDW, Hemoglobin concentration distribution width (g/dL) | 2.74 ± 0.06 | 2.34 ± 0.06 *** | 2.58 ± 0.06 | 2.85 ± 0.16 ° |
| RDW, Red blood cell volume distribution width (%) | 13.72 ± 0.35 | 12.17 ± 0.22 | 13.03 ± 0.3 | 14.35 ± 1.16 |
| WBC, White blood cell (×103/μL) | 6.0 ± 0.32 | 6.08 ± 0.39 | 6.62 ± 0.37 | 6.08 ± 0.69 |
| Lymphocyte count (×103/µL) | 4.07 ± 0.29 | 3.76 ± 0.31 | 4.67 ± 0.29 | 5.19 ± 0.37 |
| Monocyte count (×103/µL) | 0.18 ± 0.02 | 0.17 ± 0.02 | 0.15 ± 0.02 | 0.17 ± 0.02 |
| Neutrophil count (×103/µL) | 1.37 ± 0.09 | 1.69 ± 0.17 | 1.32 ± 0.12 | 1.33 ± 0.26 |
| Eosynophil count (×103/µL) | 0.18 ± 0.04 | 0.15 ± 0.02 | 0.12 ± 0.01 | 0.12 ± 0.01 |
| Basophil count (×103/µL) | 0.03 ± 0.003 | 0.04 ± 0.005 | 0.04 ± 0.006 | 0.04 ± 0.005 |
| Large unstained cell count (×103/µL) | 0.2 ± 0.04 | 0.2 ± 0.06 | 0.18 ± 0.06 | 0.14 ± 0.02 |
| PLT, Platelet count (×103/μL) | 819 ± 49.71 | 643.8 ± 26.79 | 881.7 ± 113.3 | 903 ± 56.08 |
| MPV, Mean platelet volume (fl) | 7.81 ± 0.17 | 6.93 ± 0.2 | 7.9 ± 0.41 | 8.95 ± 0.21 °° |
| Reticulocyte count (×103/µL) | 205.5 ± 13.19 | 169.7 ± 7.13 | 193.8 ± 9.58 | 225.3 ± 16.62 |
| MCVr, Reticulocyte mean corpuscular volume (fl) | 69.22 ± 0.91 | 70.13 ± 0.71 | 70.52 ± 0.95 | 71.7 ± 1.82 |
| CHCMr, Reticulocyte hemoglobin concentration mean (g/dL) | 27.2 ± 0.15 | 27.28 ± 0.2 | 26.88 ± 0.18 | 27.65 ± 0.16 # |
| CHr, Mean reticulocyte hemoglobin (pg) | 18.8 ± 0.2 | 19.05 ± 0.3 | 18.86 ± 0.26 | 19.75 ± 0.55 |
| Controls | Chronic Diabetics | Insulin-Treated Diabetics | |
|---|---|---|---|
| Echinocyte (Burr cells; %) | 2.87 ± 0.5 | 3.39 ± 0.45 | 3.01 ± 0.44 |
| Acanthocyte (Spur cells; %) | 1.24 ± 0.41 | 0.59 ± 0.16 | 2.67 ± 0.48 **°° |
| Ovalocyte (%) | 11.7 ± 1.27 | 7.51 ± 0.69 | 15.63 ± 1.48 °°°° |
| Dacrocyte (Teardrop cells; %) | 1.48 ± 0.32 | 2.48 ± 0.38 | 4.32 ± 0.7 *** |
| Schistocyte (Fragmented cells; %) | 0.67 ± 0.18 | 0.89 ± 0.19 | 1.73 ± 0.26 ** |
| Eccentrocyte (%) | 0.0 ± 0.0 | 0.61 ± 0.2 *** | 0.06 ± 0.03 °° |
| Hemolyzed RBC (%) | 0.32 ± 0.11 | 1.48 ± 0.3 *** | 0.5 ± 0.12 ° |
| Codocyte (Target cells; %) | 0.0 ± 0.0 | 8.17 ± 1.21 **** | 2.48 ± 0.36 ****° |
Disclaimer/Publisher’s Note: The statements, opinions and data contained in all publications are solely those of the individual author(s) and contributor(s) and not of MDPI and/or the editor(s). MDPI and/or the editor(s) disclaim responsibility for any injury to people or property resulting from any ideas, methods, instructions or products referred to in the content. |
© 2023 by the authors. Licensee MDPI, Basel, Switzerland. This article is an open access article distributed under the terms and conditions of the Creative Commons Attribution (CC BY) license (https://creativecommons.org/licenses/by/4.0/).
Share and Cite
Szalai, Z.; Berkó, A.M.; Bódi, N.; Hermesz, E.; Ferencz, Á.; Bagyánszki, M. Oxidative-Stress-Related Alterations in Metabolic Panel, Red Blood Cell Indices, and Erythrocyte Morphology in a Type 1 Diabetic Rat Model. Appl. Sci. 2023, 13, 9920. https://doi.org/10.3390/app13179920
Szalai Z, Berkó AM, Bódi N, Hermesz E, Ferencz Á, Bagyánszki M. Oxidative-Stress-Related Alterations in Metabolic Panel, Red Blood Cell Indices, and Erythrocyte Morphology in a Type 1 Diabetic Rat Model. Applied Sciences. 2023; 13(17):9920. https://doi.org/10.3390/app13179920
Chicago/Turabian StyleSzalai, Zita, Anikó Magyariné Berkó, Nikolett Bódi, Edit Hermesz, Ágnes Ferencz, and Mária Bagyánszki. 2023. "Oxidative-Stress-Related Alterations in Metabolic Panel, Red Blood Cell Indices, and Erythrocyte Morphology in a Type 1 Diabetic Rat Model" Applied Sciences 13, no. 17: 9920. https://doi.org/10.3390/app13179920
APA StyleSzalai, Z., Berkó, A. M., Bódi, N., Hermesz, E., Ferencz, Á., & Bagyánszki, M. (2023). Oxidative-Stress-Related Alterations in Metabolic Panel, Red Blood Cell Indices, and Erythrocyte Morphology in a Type 1 Diabetic Rat Model. Applied Sciences, 13(17), 9920. https://doi.org/10.3390/app13179920

